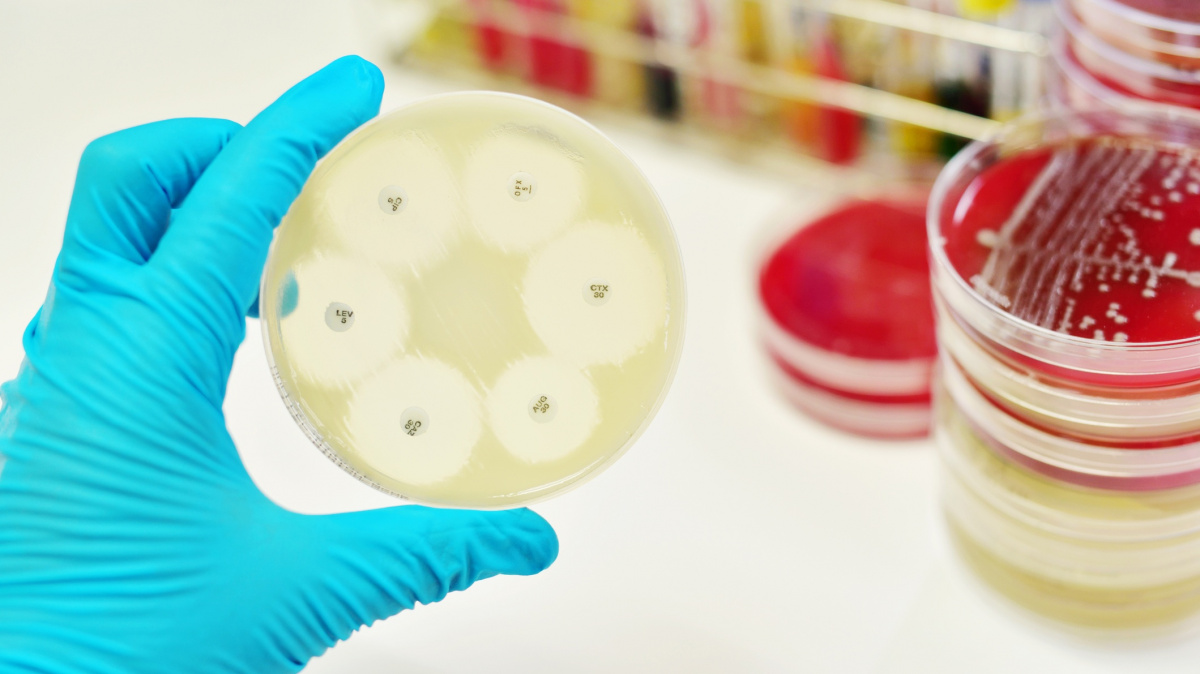

Články autora: Ladislav Loukota
Člověk
Svalovou dystrofii se podařilo vyléčit pomocí genového editoru CRISPR
17. 9. 2018
|
Ladislav Loukota
Prenatální testy odsunuly problém dědičných chorob stranou – řada těhotenství, u nichž testy riziko dědičné nemoci odhalí, je ukončeno. Přesto však takový přístup nelze považovat za "skutečné" vyléčení. To slibuje až počínající věk genových terapií. Další z nich se nyní podařilo vykurýrovat, prozatím u psů, zhoubnou Duchennovu svalovou dystrofii.
Člověk
Obchod s jantarem bujel již v prehistorické Evropě
16. 9. 2018
|
Ladislav Loukota
Jako výjimečný obchodní artikl historie máme tendenci vnímat spíše vzácné kovy - zlato, stříbro, měď. Dávno před nimi však první kultury našly zálibu v docela jiné druhu komodity. Řeč je o jantaru, ale i nefritu či obsidiánu, které bylo v dané éře snazší zpracovat a které kvůli svému vzhledu měly výjimečné postavení. Stopování toho, kterak primitivní evropské národy tisíce let před vznikem své civilizace s podobným zbožím obchodovaly, nám pomáhá ucelovat obrázek společnosti z této pradávné historie.
Technologie
Proces vypůjčený od řas by mohl napomoci vývoji umělé fotosyntézy
15. 9. 2018
|
Ladislav Loukota
Energetická krize lidské civilizace působí v řadě ohledů paradoxně. Nejenže pod našima nohama rotují obří kvanta rozžhavené horniny, ale Země navíc obíhá kolem 4,6 miliardy let explodující koule horkého plazmatu, které říkáme Slunce. I přesto máme problém z obou těchto zdrojů smysluplně získat dost energie, a jsme tak závislí hlavně na fosilním palivu vzniklém z předešlých mrtvých obyvatel planety. Na Zemi však rozhodně existuje jeden druh, který "solární energii" ke svému chodu majoritně využívá – jde o rostliny závislé na fotosyntéze. Nová studie Cambridgské univerzity přispěla k tomu, abychom jejich metodu jednou mohli začít využívat v energetice i my.
Člověk
Nové kombinace antibiotik jsou v boji s rezistencí překvapivě účinné
14. 9. 2018
|
Ladislav Loukota
Pro lidstvo je jenom málo tak závažných problémů, jako zvyšující se rezistence bakterií vůči antibiotikům. Léky, které před víc než 90 lety daly moderní medicíně její nejsilnější zbraň, ztrácejí účinnost vlivem řady faktorů. Všechny ale mají společného jmenovatele v přirozeném vývoji odolnosti bakterií. Právě proto se alternativa antibiotik hledají tak obtížně. Nová kalifornská práce však přichází s novou, nečekanou zbraní proti rezistenci.
Technologie
Roje nanostrojů umožní v těle provádět operace bez skalpelu
12. 9. 2018
|
Ladislav Loukota
Co kdybychom kvůli odříznutí škodlivé tkáně nemuseli otevírat pacientovo tělo, ale mohli skalpel "sestavit" uvnitř těla samotného? Právě tímto směrem kráčí aktuální čínská studie, které se podařilo dosáhnout pokroku na poli manipulace a kontroly nanočástic. Je to už třetí významný pokrok v medicínské nanotechnologii v tomto roce.
Technologie
Japonci vyzkouší vesmírný výtah. Jeho využití se ale v tomto století nejspíš nedočkáme
11. 9. 2018
|
Ladislav Loukota
Chystá se první test technologií kosmického výtahu ve vesmíru! Podle japonské univerzity z Šizouky bychom se ho mohli dočkat již v polovině září tohoto roku, kdy se do vesmíru na palubě nosiče H-2B podívá malý výtah pohybující se na lanu mezi dvěma satelity. Test odolnosti materiálu je sice sympatickým vědeckým experimentem, který muže přinést zajímavá data, v dohledné budoucnosti od něj však praktické výsledky nejspíše očekávat nelze.
Příroda
Změna magnetického pole Země může trvat jen 200 let
9. 9. 2018
|
Ladislav Loukota
Magnetosféra je považovaná za nejvýraznějšího přirozeného ochránce pozemského života před nebezpečnou kosmickou radiací. Co však může nastat, když jednou kvůli přepólování o tuto ochranu Země přijde?
Nedd
Naše galaxie již možná jednou 'zemřela', nyní žije druhý život
8. 9. 2018
|
Ladislav Loukota
Při pohledu ze Země může vesmír působit jako nehybný černý monolit, opak je však pravdou. Například rozsáhlé oblasti naši galaxie se vyznačují dvěma hlavními hvězdnými populacemi. První skupina hvězd je bohatá na prvky, jako je kyslík, hořčík, křemík, síra, vápník a titan. Skupině druhé se těchto prvků dostává povážlivě méně, zato jsou však tyto hvězdy bohatší na železo. Rozdělení obou skupin naznačuje, že obě vznikly v radikálně odlišném kontextu v rámci celé galaxie. Doposud se přesně nevědělo, co by mohlo být jeho příčinou. Objevují se však indicie, že odpověď by mohla tkvět v sáhodlouhém období galaktické 'smrti' a proudění mezihvězdného plynu.